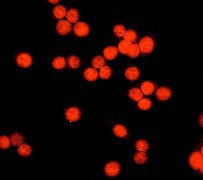

> Antigen, Antibodies, ELISA, Western Blot > Primary Antibody > Monoclonal Antibodies > Histone Deacetylase 3 Antibody (C-term)Brand |
Leading Biology | Catalog Number |
APR07752G |
Product Type |
Monoclonal Antibodies | Field of Research |
|
Product Overview |
We constantly strive to ensure we provide our customers with the best antibodies. As a result of this work we offer this antibody in purified format.
We are in the process of updating our datasheets. If you have any questions regarding this update, please feel free to contact our technical support team.
This product is a high quality Histone Deacetylase 3 antibody (C-term).
|
||
Molecular Weight |
48848 Da
|
||
Cellular Localization |
Antigen Cellular Localization:
Nucleus. Cytoplasm. Note=Colocalizes with XBP1 and AKT1 in the cytoplasm (PubMed:25190803).
|
||
Host |
Rabbit
|
||
Species Reactivity |
Human, Mouse, Rat
|
||
Target |
A synthetic peptide corresponding to residues in the C-term of human Histone deacetylase 3 was used as immunogen. This antibody may detect splice isoform 2 (RPD3-2A).
|
||
Clone |
Y415
|
||
GeneID |
|||
UniProt ID |
|||
Function |
Responsible for the deacetylation of lysine residues on the N-terminal part of the core histones (H2A, H2B, H3 and H4), and some other non-histone substrates. Histone deacetylation gives a tag for epigenetic repression and plays an important role in transcriptional regulation, cell cycle progression and developmental events. Histone deacetylases act via the formation of large multiprotein complexes. Participates in the BCL6 transcriptional repressor activity by deacetylating the H3 'Lys- 27' (H3K27) on enhancer elements, antagonizing EP300 acetyltransferase activity and repressing proximal gene expression. Probably participates in the regulation of transcription through its binding to the zinc-finger transcription factor YY1; increases YY1 repression activity. Required to repress transcription of the POU1F1 transcription factor. Acts as a molecular chaperone for shuttling phosphorylated NR2C1 to PML bodies for sumoylation (PubMed:21444723, PubMed:23911289). Contributes, together with XBP1 isoform 1, to the activation of NFE2L2-mediated HMOX1 transcription factor gene expression in a PI(3)K/mTORC2/Akt-dependent signaling pathway leading to endothelial cell (EC) survival under disturbed flow/oxidative stress (PubMed:25190803).
|
||
Summary |
Histone deacetylase 3 belongs to the histone deacetylase family type 1 which actively deacetylate Histones. Currently 3 known isoforms exists (HDAC3, HDAC3A and HDAC3C) (1). HDAC3 represses transcription and binds transcription factor YY1 to form a large complex. N-Cor binds HDAC3 in a different manner than other HDACs. In addition to N-Cor, HDAC3 will form a complex with corepressor SMRT (2). HDAC3 is also known to interact with DAXX, HDAC10 and DACH1.
|
||
Form |
50 mM Tris-Glycine (pH 7.4), 0.15 M NaCl, 40% Glycerol, 0.01% sodium azide and 0.05% BSA. |
||
Storage & Stability |
Store at +4°C short term. For long-term storage, aliquot and store at -20°C or below. Stable for 12 months at -20°C. Avoid repeated freeze-thaw cycles.
|
||
Applications |
WB, IHC, IF
|
||
Dilution |
WB~~1:500
IHC~~1:250~500
|
||
Synonyms |
Histone deacetylase 3, HD3, RPD3-2, SMAP45, HDAC3
|
||
Images |

A. Western blot analysis on K562 cell lysate using anti-Histone Deacetylase 3 (C-term) RabMAb (Cat. APR07752G), 1:10,000 
B. Immunohistochemical analysis of paraffin-embedded human ovary carcinoma using anti-Histone deacetylase 3 (C-term) RabMAb (Cat. APR07752G).
C. Immunofluorescent staining of HeLa cells using anti-Histone deacetylase 3 (C-term) RabMAb (Cat. APR07752G). |
||
Specification |
|||
Quantity |
|
||
| Select | Brand | Catalog No. | Product Name | Pack Size | Type | Field of Research | Specification | Quantity | Price(USD) | |
| 1 | Leading Biology | APG02467G | CCK4 / PTK7 Antibody (clone 4F9) | 50 μl | Monoclonal Antibodies |
|
$495.00 | Add Ask | ||
| 2 | Leading Biology | AMM04683G | GALT Antibody (clone 4C11) | 50 μg | Monoclonal Antibodies |
|
$545.00 | Add Ask | ||
| 3 | Leading Biology | AMM01402G | Vimentin (Mesenchymal Cell Marker) Antibody - With BSA and Azide | 50 ug | Monoclonal Antibodies |
|
$395.00 | Add Ask | ||
| 4 | Leading Biology | APR08280G | LTA4H / LTA4 Antibody (clone 9G8) | 50 μl | Monoclonal Antibodies |
|
$495.00 | Add Ask | ||
| 5 | Leading Biology | AMM00172G | CD1a / HTA1 (Mature Langerhans Cells Marker) Antibody - With BSA and Azide | 50 ug | Monoclonal Antibodies |
|
$395.00 | Add Ask | ||
| 6 | Leading Biology | AMM05750G | CEBPA Antibody | 100 μl | Monoclonal Antibodies |
|
$545.00 | Add Ask |
 Leading Biology Inc.
2600 Hilltop DR, Building G, B Suite C138
Richmond, CA, 94806
Tel: 1-661-524(LBI)-0262
Email: info@leadingbiology.com
Leading Biology Inc.
2600 Hilltop DR, Building G, B Suite C138
Richmond, CA, 94806
Tel: 1-661-524(LBI)-0262
Email: info@leadingbiology.com
Complete this form and click send to ask us a question, request a quote or simply say hello.

You have 0 item in your cart

You have 0 item in your inquiry list
